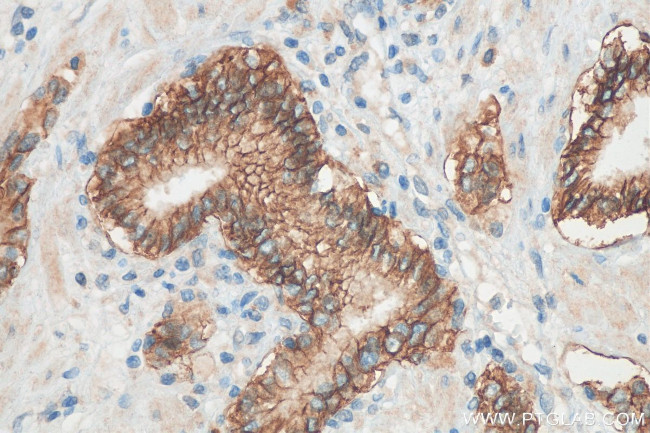
TACSTD2/TROP2 Antibody in Immunohistochemistry (Paraffin) (IHC (P))

Search
Proteintech
TACSTD2/TROP2 Polyclonal Antibody
{{$productOrderCtrl.translations['antibody.pdp.commerceCard.promotion.promotions']}}
{{$productOrderCtrl.translations['antibody.pdp.commerceCard.promotion.viewpromo']}}
{{$productOrderCtrl.translations['antibody.pdp.commerceCard.promotion.promocode']}}: {{promo.promoCode}} {{promo.promoTitle}} {{promo.promoDescription}}. {{$productOrderCtrl.translations['antibody.pdp.commerceCard.promotion.learnmore']}}
图: 1 / 5
TACSTD2/TROP2 Antibody (27360-1-AP150UL) in IHC (P)





产品信息
27360-1-AP150UL
种属反应
宿主/亚型
分类
类型
偶联物
形式
浓度
规格
纯化类型
保存液
内含物
保存条件
运输条件
靶标信息
TROP2 is a carcinoma-associated antigen defined by the monoclonal antibody GA733. This antigen is a member of a family including at least two type I membrane proteins. It transduces an intracellular calcium signal and acts as a cell surface receptor. Mutations of its gene result in gelatinous drop-like corneal dystrophy, an autosomal recessive disorder characterized by severe corneal amyloidosis leading to blindness.
仅用于科研。不用于诊断过程。未经明确授权不得转售。
篇参考文献 (0)
生物信息学
蛋白别名: 40kD glycoprotein, identified by monoclonal antibody GA733; Cell surface glycoprotein Trop-2; cell surface glycoprotein TROP2; epithelial glycoprotein-1; GA733; gastrointestinal tumor-associated antigen GA7331; Membrane component chromosome 1 surface marker 1; membrane component, chromosome 1, surface marker 1; Pancreatic carcinoma marker protein GA733-1; pancreatic carcinoma marker protein GA7331; TACD2; TACSTD2; trophoblast cell surface antigen 2; Tumor-associated calcium signal transducer 2; unnamed protein product
基因别名: EGP-1; EGP1; GA733-1; GA7331; GP50; M1S1; TACSTD2; TROP2
UniProt ID: (Human) P09758
Entrez Gene ID: (Human) 4070